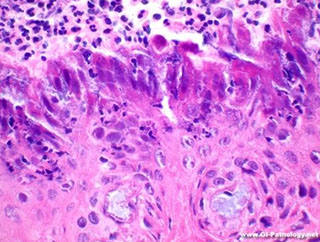
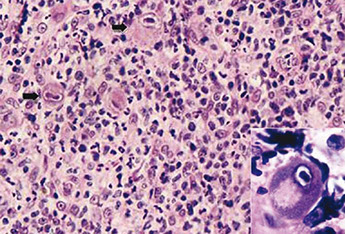
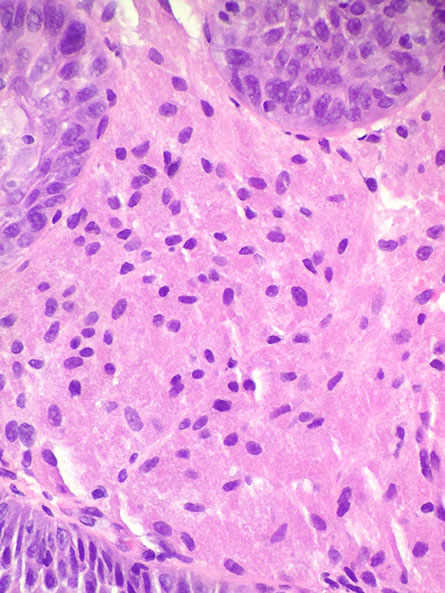

Esophagus
Embryology, Anatomy, Histology
Biopsy interpretation
Inlet patch (Cervical gastric heterotopia)
Pancreatic acinar cell metaplasia / heterotopia
Foveolar epithelium
Heterotopic sebaceous glands
Esophageal melanocytosis / melanosis
Glycogenic acanthosis
Esophageal leukoplakia
Chemical / physical injury
Achalasia
Webs and Rings
Zenker's diverticulum
Eosinophilic esophagitis
Esophageal varices
Boerhaave syndrome
Mallory-Weiss syndrome
Gastoesophageal Reflux Disease (GERD)
Esophagitis Dessicans Superficialis (EDS)
Ulcers / polyps with atypical stromal cells
Multinucleated epithelial giant cell change
Graft versus host disease
Dermatologic disease in the esophagus
Esophageal infections
Crohn disease of the esophagus
Esophageal atresia
Lymphocytic esophagitis
Common variable immunodeficiency (CVID)
Post-treatment Changes
Endoscopic Mucosal Resection Specimens
Squamous Papilloma
Giant Fibrovascular Polyp
Intestinal Metaplasia
Barrett's esophagus
Esophageal cancer overview
Intramucosal Carcinoma
Variant Patterns of Dysplasia
Adenocarcinoma
Squamous cell carcinoma
Neuroendocrine Tumors
Granular cell tumor (GCT)
Rhabomyoma
Leiomyoma
Esophageal GIST
Melanoma
Nerve Sheath Tumors
Esophagus
Esophageal Embryology
Technically from pharynx (cricoid cartilage) to stomach
From columnar foregut endoderm; after vacuolization at ~7 WGA, ciliated cells show up in middle 1/3 and spread up and down.
Stratified squamous then shows up at 20 WGA and also spreads up and down, getting rid of the ciliated cells
- process finished in upper esophagus couple days after birth (also may persist into adulthood or undergo metaplasia back into ciliated cells)
-- squames could be the source of esophageal cardiac glands
Upper 1/3 striated muscle; middle 1/3 mixed muscle; lower 1/3 smooth muscle [???]
Neural crest cell migration gives neural cells at ~ 4 WGA, first myenteric, then submucosal
- Cajal interstitial cells at 9 WGA; cahoots w/ myenteric plexus
Circular then long. muscle at 6/9 WGA respectively
Errors in any part of this process may occur
Esophageal Anatomy
~25 cm musclar tube that connects to the cardia of stomach
- measured by endoscopists by distance from incisors (~40 cm)
- rich in lymphatics (also in the stomach and sm intestine)
- upper portion has sk muscle, c parasymp innervation by vagus n and symp innervation c cervical and paravertebral ganglia
3 constrictions: Upper Esophageal Sphincter (UES, cervical constriciton, cricopharyngeal muscle), Broncho-aortic (thoracic) constriction and Lower Esophageal Sphincter (LES, Diaphragmatic constriction)
Esophagogastric junction is jagged line immediately below LES where esophageal squamous mucosa turns into gastric cardia
Abdominal postion of esophagus supplied by left gastric artery and left inferior phrenic artery; drained by esophageal veins into azygous veins; cervical portion supplied by inf thyroid a., upper 2/3 drained by inf thyroid vein
- lymph from this part drains into left gastric LNs and into celial LNs
- esophagus innervated by esophageal plexus from vagal trunks and thocacic sympathetic trunks from greater splanchnic nerves
Esophageal Histology
4 histo layers: mucosa, submucosa, muscularis propria, adventitia
- there is no serosa in the esophagus, which is important in staging
- mucosa heaped up in folds c lots of turnover and mitotically active basal layer
Mucosa
longitudinal folds of nonkeratinized stratified squamous; with lamina propria and muscularis mucosae underneath
- stratified squamous layer: Basal, prickle, and functional layers
-- interspersed endocrine cells ((+)-argyrophilic), melanocytes (melanosis), Merkel cells, intraepithelial mononuclear cells, squiggle cells (lymphs in suprabasal region); Langerhan's cells
- basal cells are glycogen poor (vs prickle and functional layers, >15% mucosal thickness in reflux), whereas the surface cells glycogenated;
Lamina propria: btw muscularis mucosa and squamous epithelium; has areolar CT, VANs, lymphos, mucus glands
--cardiac-type mucus glands scattered throughout esophagus, MC inferiorly, have parietal and chief cells and Paneth-like granules
-- papillae: extensions of lamina propria into mucosa; shouldn't extend into upper 1/3 of mucosa
Muscularis mucosa: longitudinal SM that not found superiorly and thickens near stomach (may confuse with muscularis propria)
- should not see lymphoid or plasma cells
- may thicken or duplicate with injury, which can be mistaken for muscularis propria
Submucosa
Loose CT with VANs (+ Meissner's plexus), glands
- submucosal glands: helps lubricate for food passage
-- lined w/ squames, thought to be continuation of minor salivary glands; acidic mucinous cells w/ little serous part and bicarb (protective), not seen in stomach, usually not in bx's
-- can undergo oncocytic changes
- submucosal venous plexus most prominent near stomach
Muscularis propria
Inner circular and outer longitudinal layers
- striated in upper 1/3 (usually only a short segement), next 1/3 mixed, then predominantly SM in lower 1/3; Auerbach's here
- consider calling clinician if muscularis propria seen on standard bx bc may have perforated
Adventitia
Not present throughout (only below diaphragm?); majority of esophagus surrounded by fascial layer
Normal (?) Anatomic Variations
Glycogenic acanthosis: Little white bumps in 1/4 of people.
- prickle layer cells have lots of glycogen and undergo hyperplasia
- don't confuse w/ monilial plaques or leukoplakia
Heterotopias: cells outside of normal place; see discoloration
- can see pancreas, gastric, sebaceous,
Zenker's diverticulum: may form from area where muscle layers intrinsically thin (area of Laimer)
Shatzki's ring may cause the GE junction to be straight, not serrated
Biopsy interpretation
Should look up endoscopy results; note the location of the bx and how close to the GE junction
Things to check for at low power:
- is there parakeratosis? (can have Candida)
- is the mucosa hyperplastic? (glycogenic acanthosis has hyperplastic mucosa c clear cell features; granular cell tumor is hyperplastic c repair)
- is it ulcerative? (think infx)
Considerations on GE junction bx's (from Appleman and Greenson)
- gastic-type mucosa present w/o goblet cells, if it is cardia, then most likely has inflam; though most cases of mild carditis do not have a known cause consider reflux or H pylori (if no orgs seen dx "carditis of unknown etiology"), if mucosa is oxyntic may be 2/2 hiatal hernia
- diagnose Barrett's esophagus and state the degree of dysplasia (none, indefine, low- or high-grade) if goblet cells c mucosa from endoscopic tongues that the endoscopist reports as Barrett's
- goblet cells c mucosa, but tongues not seen on endoscopy despite having prominent Z-line, dx as "goblet cells at the cardia", not sure whether IHC can further help in delineating dz
- goblets cells c mucosa, but endoscopist unsure if there are tongues or prominent Z-line, dx "goblet cell containing mucosa, either Barrett mucosa or goblet cells at the cardia" and include if there is dysplasia (pathologist cannot be sure if endoscopist is not sure)
Inlet patch (Cervical gastric heterotopia)
Bx site 15-20cm, in upper or mid esophagus, c segment of normal sq esophagus and gastric type mucosa
- may be embryologic vestige from when esophagus lined by columnar epithelium; seen in up to 1/10 pts
- seen in cervical esophagus; usually no sx, though can be assoc c local injury (webs, rings, ulcers, fistulas) that cause sx; ca is rare
Micro: columnar oxyntic mucosa c parietal cells; may be transitional or cardiac pattern
- may have H pylori or intestinal metaplasia
- can also have pancreatic tissue
Pancreatic acinar cell metaplasia / heterotopia
Acinar cells or nodules of pancreatic ductal structures c a few acinar cells found c some frquency in distal esophagus
- may be asx or in pts c reflux
- no inc risk of ca
- most likely a heterotopia and not metaplasia
- may look like gastric oxyntic mucosa at low power
Foveolar epithelium
Histologically has foveolar mucin cap
- some cells can look pleomorphic and raise concern for intestinal metaplasia
- IHC: PAS/AB shows alcianophilic staining of consecutive foveolar cells (instead of discrete goblet cells stained in true intestinal metaplasia)
Heterotopic sebaceous glands
very rare; assoc c reflux sx, adb pain, peptic ulcer
- grossly slightly raised yellow plaques or nodules
- most likely a metaplstic process and not a heterotopia bc has not been found in children and sebaceous glands derived from ectoderm and esophagus from endoderm
Micro: lobules of large polygonal clear cells c vacuolated cytoplasm in lamina propria surrounded by chronic inflam; not assoc c hair follicles
- may be connected to luminal surface by sq-lined duct c granular layer
Esophageal melanocytosis / melanosis
Rare, in middle-aged men, usually middle-lower 1/3 of esophagus, grossly are black or blue mucosal macules
Micro: inc melanocytes in epithelial basal layer, which have inc melanin, long dendritic processes extending bwt keratinocytes, and lacking desmosomes and tonofilaments, nuclei are small and a little darker than surrounding keratinocytes, no nucleoli or atypia
- stain c melanocytic markers (S100, Melan-A, HMB45)
- underlying lamina propria has brown-black pigment-laden macrophages
- overlying epithelium can have reactive basal hyperplasia, acanthosis, or hyperkeratosis, but looks mature
- probably not assoc c inc risk of melanoma
Glycogenic acanthosis
Common, single to multiple gray-white plaque c lots of intracellular glycogen deposits; grossly may be described as cobble-stoning
- not assoc c ulcers, dysmotility or stenosis, tho may be assoc c celiac dz in peds, and is assoc c Cowden dz if diffuse
- may be found in areas surrounding SCC, but usually incidental
- may be confused c Candida by endoscopist
Esophageal leukoplakia
Persistent white patch usually in the mouth that has hyperkeratosis
- pretty rare in esophagus, but if present usually more prominent in distal 1/3 of esophagus; may be caused by chronic irritation
- may have assoc c dysplasia / ca; pt may need inc surveillance
Micro: epithelial hyperplasia and parakeratosis usually c inflam
- can have sharp demarcation vwt thick basal layer and acanthotic midzone c vacuolated cells and third superficial parakeratotic layer
Chemical / physical injury
Iron
Can cause corrosive injury to esophagus (erosion / ulcer)
- may be tx'd by crughing the pill and ingesting c a soft food
- micro: blue-brown luminal crystalline iron adjacent to surface or mixed c fibroinflam exudates
- iron can be in lamina propria next to small erosions or mixed c granulation tissue; can even have thrombi of the crystalloids
- iron stain may help to highlight
Kayexalate (sodium polystyrene sulfonate)
Cation-exchange resin used for hyperkalemia, can be given by enema; usually given in suspension c hypertonic sorbitol (reducing incidence of kayexalate bezoar formation in stomach by causing hypertonic diarrhea; may be assoc c UGI damage or colonic necrosis)
- micro: light blue crystals, can be bile-pigmented; have fish-scale mosaic pattern of crystals (which are refractile but not polarizable)
Taxol
Causes mitotic arrest c epithelial necrosis and eosphageal ulceration and duodenal necrosis
- binds to microtubules, causing polym,erization and inhibiting depolymerization
- micro: arrested mits in proliferative zone c ring forms
- colchicine MC affects the small intestines and histologic changes only seen in colchicine toxicity (may req supportive care)
Mycophenolate
Immunosuppressive agent that is a fermentation product of Penicillium brevicompactum siolated in 1989
- used in transplants, nephritis, uveiitis, vasculitis, pemphigus
- can be mycophenolate mofetil (absorbed in stomach) or mycophenolate sodium (enteric coated and absorbed in small intestines)
- inhibits de novo pathway of purine synth by inhibiting guanosine synth through inosine monophosphate (IMP) inhibition, which is needed by B and T-cells, and to a lower degree by enterocytes
- micro: similar pattern as GVHD, c crypt apoptosis, crypt distortion, cellular reparatie changes and inc NE cells
- in esophagus, can see >2 apoptotic bodies / 10 hpf
Fosamax (bisphosphonates)
- prevent osteoclast-mediated bone reabsorption; avoid using these meds in pts c extreme reflux or motility disorders, probably no inc risk of ca
- assoc c (pill) esophagitis and ulcers in upper GI
- may see polarizable crystals c assoc MNGCs
Corrosives (ie Lye or blea)
No specific injury pattern; severe ulceration seen on endoscopy
- may see extensive necrosis
- pts may have severe strictures if they survive and are thus at inc risk of SCC and need extensive f/u
Achalasia
from Greek: A- (not); chalao (loosen / relax)
MCC Neuromuscular disorder of esophagus
inc LES tone from impaired sm muscle relaxation
Primary achalasia 2/2 degeneration of inhibitory neurons in distal esophagus
Secondary achalasia can be in Chagas, where LES fails to relax b/c destruction of myenteric (Auerbach's) plexus.
- inflam. of esophageal myenteric plexus is pathomneumonic
- damage to inhibitory (NO synthase producing) neurons
- can also be seen in DM, malig, amyloidosis, sarcoidosis, polio, surgical ablation of nerves, Down syndrome, Allgrove syndrome
Triad:
1)incomplete LES relaxation,
2) inc LES tone
3) esophageal aperistalsis
High LES opening pressure + uncoordinated peristalsis --> progressive dysphagia to solids AND liquids
- dysphagia limited to solids indicates an obstructive lesion
Primary achalasia 2/2 ganglion cell degen (inhibitory neuron degeneration, thus inc tone)
May be caused by Chaga's dz./ Scleroderma (CREST syndrome), diabetic neuropathy, or amyloidosis
Generally, worsening dysphagia to solids and liquids indicates motility disorders --> achalasia, MG, stroke, CREST syndrome
- Dysphagia limited to solids indicates an obstructive lesion (ie an esophageal web / cancer)
- drugs that cause esophagitis: tetracyclines, aspirin / NSAIDS, alendronate, KCl, quinidine, iron
Dx: Manometry studies. Barium swallow shows "bird's beak" (stenosis of distal esophagus).
- manometry findings: 1) Aperistalsis; 2) dec LES relaxation after swallowing; 3) inc LES resting tone
Tx: 1) Pneumatic balloon dilation (may cause rupture)
2) Botulinum toxin injection to LES
3) Esophagotomy
Px: small (1/20) risk of esophageal SCC
- thus pt should get bx more frequently (annually?)
Esophageal Webs and Rings
Ledges of mucosa that protrude into lumen
- called webs if seen in prox esophagus and Schatzki rings if in distal esophagus or GE junction
- Plummer-Vinson syndrome is upper eso web in middle-aged or older women c iron deficiency anemia, glossitis and cheilosis and has inc risk of SCC in postcicoid esophagus
Micro: usually not too many findings, but can have parakeratosis from mechanical damage by food, but can have erosions or assoc Candida
Zenker's (pharyngoesophageal) diverticulum
False esophageal diverticulum prox to cricopharyngeal muscle due to inc esophageal pressures
- herniation of mucosal tissue (false diverticulum)
-- occurs at junction of pharynx and esophagus; herniated backward through cricopharyngeal muscle fibers
- may be related to traction (mid-esophagus) and epiphrenic (lower esophagus) diverticuli
Sx: Halitosis (due to trapped food particles); dysphagia / obstruction
Tx:surgical excision and, frequently, cricopharyngeal myotomy
Eosinophilic / allergic esophagitis (EE)
Dysphagia / GERD sx in kids and young adults, usually atopic c hx of allergy, asthma, drug sensitivity, eosinophilia in PB, inc IgE that present c diarrhea, malabsorption, depending on site involved
- incidence is increasing rapidly!!!, benign; but freq is increasing; may be assoc c ingestion of food / inhalants that cause allergic rxn; can affect any part of the GI (and all parts of the esophagus are generally involved)
See multiple mucosal rings (linear furrows), esophageal trachealization, feline esophagus, white mucosal specs or normal on endoscopy
- prone to endoscopic complications (spontaneous rupture), maybe 2/2 eo involvement in submucosa
Micro: lots of eos, possibly in clusters of >15/hpf (microabscesses)
-- must be careful in interpreation of counts bc severe GERD can have this level of eos as well; may suspect EE is eos >8/hpf, can be more sure if >24 / hpf esp if in upper- / mid-esophagus
- basal zone hyperplasia
- lots of overlap c reflux esophagitis (eosinophils most increased at base of mucosa); but should just note if there is inc eos and not definitively dx EE, bc allergic / reactive reactions can be identical
Tx: avoidance of substances that set it off (milk / soy)
- may give roids
Esophageal varices
Venous blood from GI tract passes through liver via portal vein before returning to heart (responsible for first-pass effect in which drugs and other materials absorbed in intestines)
- dz's that cause portal hypertension lead to development of esophageal varices, collateral channels develop at sites where portal and caval systems communicate
- MCC is alcohol (in 1/2 of pts c cirrhosis), 2nd MCC is hepatic schistosomiasis
- can cause painless bleeding of submucosal veins in lower 1/3 of esophagus; 1/3 of pts c bleeding die as a result of hemorrhage, and most pts who survive get recurrent bleeding in the first year
- tortuous and dilated veins in submucosa of distal esophagus
- asymptomatic until varices rupture
- collateral channels form at portal-caval communication points
- Grossly - may not be visible in surgical or postmortem specimens bc veins collapse without blood flow and are obscured by the mucosa
MCC death in pts c cirrhosis
Tx / prevention: B-blockers (propanolol / nadolol), octreotide, TIPS and endoscopic variceal ligation
Px: 1/3 die of hypovolemic shock in first episode; 1/2 get another episode of bleeding during 1st year and again have 1/3 mortality
Boerhaave syndrome
Transmural esophageal rupture 2/2 violent retching and (MCC) endoscopy; causes severe mediastinitis
*** Bore-Hole syndrome***
Rupture of esophagus --> pneumomediastinum (air in subQ tissue of ant mediastinum); visible on chest CT, causes tachypnea, shock and can look clinically like an MI
- Life threatening!!! needs surgery pronto
Mallory-Weiss tears
Painful longitudinal, linear mucosal lesions at GE junction from severe vomiting which promotes hematemesis
- seen in alcoholics and bulemics
- 75% also have a hiatal hernia
- may be 2/2 failure of relaxation of the muscle of esophagus during prolonged vomiting causing esophageal wall to stretch and tear
- tears usually cross the GEJ
Dx: endoscopy
Tx: usually self-limiting (vs transmucosal tearing in Boerhaave's)
Gastroesophageal Reflux Disease (GERD)
Common outpt dx; MCC of esophagitis, caused by LES incompetence, transient LES relaxation or a hiatal hernia
- pts complain of heartburn, dysphagia, sour-tasting gastric contents
- refluxed material can have duodenal contents c gastric secretions
- duodenal contents may be inc in pts taking PPIs (bile is a carcinogen; pts s/p cholecystectomy have inc risk of upper GI ca 2/2 constant draining of bile rather than in pulses, Roux-en-Y can dec dysplasia)
- Barrett esophagus seen in 1/10 cases of reflux
Risk factors: smoking, obesity, pregnancy, foods that dec LES tone (EtOH, medication, preg, hypothyroidism, scleroderma), hiatal hermias, delayed gastric empyting
~ occurs after large, fatty meals and is relieved by antacids
- cause up to 80% of esophageal strictures
Micro: classic changes are basal cell hyperplasia (reactive change, >1/5 thickness of epithelium), elongation of vascular papillae (>2/3 of epithelial thickness), and intraepithelial eos and lymphs; usually not prominent inflam (except in severe cases)
- can have ulcers, intraep lymphs, or balloon cells (distended cells c lots of pale pink cytoplasm), vascular lakes (dilated small bv's)
- severe injury can have mucosal sloughing c erosions or ulcers
- if more severe, may see inc in eos
Tx: lifestyle changes - dec bad food / substance intake, avoid lying down for 3 hours after meal and keep head elevated
- Rx: PPIs, histamine-receptor blockers, and antacids
-- if no response, Nissen / endocinch
t










Inlet patch

Inlet patch (bx taken from upper esophagus)

Squamous mucosa c marked degenerative epithelial changes. Superficial aspect c loss of cytologic detail, similar to diathermy artifact seen c snare cautery


Sq mucosa c marked acute suppurative intraepithelial inflam and secondary degenerative changes, reminiscent of iscemic changes

Pill esophagitis. Fragments of squamous mucosa c adherent luminal fibrinopurulent exudate

Kayexalate esophagitis


Eosinophilic esophagitis


Esophageal varices. A) Though no longer used as a diagnostic approach, this angiogram demonstrates several tortuous esophageal varices. B) Collagpsed varices are present in this postmortem specimen corresponding to the angiogram on A. The polypoid areas represent previous sites of variceal hemorrhage that have been ligated c bands. C) Dilated varices beneath intact squamous mucosa


mixed acute and chronic inflammatory cells in the epithelium and lamina propria along with reactive epithelial changes. Note basal and supra-basal cell hyperplasia and elongation of the lamina propria papillae. Inflammation is seen both within the epithelium and in the lamina propria.
GERD histology


An important histologic feature of reflux esophagitis is the elongation of lamina propria papillae to reach as high as the top 1/3 of the squamous epithelial thickness. Focal surface erosion is also seen at the left upper corner.
Esophagitis Dissecans Superficialis (EDS)
aka "Sloughing esophagitis"
Rare
See sloughing of large fragments of esophagus' squamous mucosa or white streaking (pseudomembranes) of any part of esophagus on endoscopy
- pt may present c vomiting of fragments of esophageal skin, or c dysphagia, or may even be completely fine
Unknown etiology
- may be result of previous endoscopy or polypharmacy f(should ask clinician)
Micro: will have some degree of intaepithelial splitting above basal layer, mummification of superficial sq epithelium c ghost nuclei
- most have some degree of parakeratosis, but not spongiosis
Ultrastructurally, decrease in desmosomes in the basal layer
Px: most cases resolve spontaneously, though more pernicious outcomes have been reported (up to 25% mortality!!)
- should discontinue meds that may provoke this condition as well as acid suppression (PPIs)
Am J Surg Pathol. 2009; 33(12):1789-94
Ulcers / polyps with atypical stromal cells
After injury fibroblasts prolif and can have atypical features (probably caused by hypoxia); area of damage can have pseudoepitheliomatous epithelium;
- stromal cells called "pseudosarcomatous changes" or "deceptive bizarre stromal cells"; usually seen at interface bwt viagle granulation tissue and necroinflam ulcer, which is more hypoxic
- Micro: similar to radiation changes, has low N:C ratio even though enlarged
- IHC: vimentin-(+) only
- negative S100, muscle markers, keratins, endothelial markers
- can ask for re-biopsy if not sure if ca or not
Multinucleated epithelial giant cell change
sometimes seen c reparative change assoc c reflux, radiation, rx or infx
- micro: multiple MN sq epithelial cells usually cinfined to basal zone c nuclei c single or many red micronucleoli c perinucleolar halo but w/o inclusions, hyperchromaticity, or atypical mits
Graft versus host disease (GVHD)
Similar to GVHD elsewhere c inc intrapithelial lymphs, basilar vacuolization, prominent epithelial apoptosis and necrosis (if severe)
- on rads or endoscopy can have bullae, desquamation, webs and strictures
-- webs or strictures in upper or mid 1/3 is sufficient to dx chronic GVHD
- can be graded as mild, moderate or severe (c ulcers / erosions), and should compare to previous bx's
Dermatologic disease in the esophagus
Can see pemphigus vulgaris (PV), paraneoplastic pemphigus, mucous membrane pemphigoid, epidermolysis bullosa, lichen sclerosus, lichen planus, TEN
Lichen planus
- cutaneous lichen planus has eruptions of violaceous scaling ppapules and plaques that are pruritic (usually on extensor surfaces of legs and forearms); if mucosal, usually in middle-aged women, and usually oral; may be in up to 1/2 of pts c cutaneous dz; endoscopically see mucosal stripping, hyperemia, submucosal plaques in upper to mid esophagus, may cause persistent dysphagia from stricture formation; microscopically see lichenoid infiltrate under epithelium of variable thickness, parakeratosis, lack of hypergranulosis; epithelium is atrophic and can see Civatte bodies (bright red); should treat systemically to avoid strictures
Pityriasis lichenoides
comprised of a group of 3 dz's on a spectrum including pityriasis lichenoides chronica, pityriasis lichenoides et varioliformis acuta, and febrile ulceronecrotic Mucha-Habermann disease
- has not been reported in the esophagus (??)
Pemphigus vulgaris and bullous pemphigoid
PV us MC form of pemphigus that involves mucosal membranes; sx are odynophagia and dysphagia, usually occur c dz in other organs
- bullous pemphigoid doesn't affect esophagus as much
Esophageal infections
Cytomegalovirus (CMV)
Should bx the base of ulcer in erosive esophagitis to detect
- usually has macrophages in perivascular distribution in granulation tissue
- consider in immunosuppressed pts; usually causes more shallow ulcers than those seen in HSV
- can be found in BV wall
Herpes Simplex Virus (HSV)
Found in the epithelium of ulcer, usually has prominent mononuclear infiltrates (viral cytopathic effect may not be present)
- usually causes punched-out ulcers endoscopically
Candida
Organisms is usually sloughed and incrusted c inflam c lots of yeast and pseudohyphal forms present, though may be helpful to thoroughly search and stain c PAS areas of parakeratosis (need pseudohyphal forms to dx)
- in advanced form, can cause gray pseudomembranes
- MCC of esophagitis in AIDS pts (followed by CMV and herpes)
Bacterial esophagitis
Should be considered in immunocomp pts c odynophagia and presence of bacteria w/o fungi or ca seen
- may be cause of occult sepsis
Crohn disease of the esophagus
may be seen in up to 1/10 pts c Crohn dz
- usually assoc c advanced dz in rest of GI; though not unusual to see microscopic dz in absence of endoscopic or radiologic dz
- advanced dz can have pseudomembranes, progressive strictures, mucosal bridges
Micro: epithelioid granulomas diagnostic in right clinical setting
- focal mononuclear cell and histiocyte infiltration to lamina propria
- may just have predominant lymphocytic esophagitis
Px: not likely to progress to more overt dz; most are not recurrent
Esophageal atresia
Thin, noncanalized cord replaces a section of esophagus, usually around the tracheal bifurcation; seen in ~1/4000 live births
- most often assoc c a fistula connecting the upper or lower esophageal pouches to a bronchis or the trachea
- may also have a fistula without atresia
>90% assoc c syndrome, esp the VACTERL sequence (vertebral, anal, cardiac, tracheal, esophageal, renal, and limb)
- often presents c polyhydramnios; may present as difficulty c feeding (vomiting), and can cause aspiration, suffocation, pneumonia, or electrolyte imbalances
- often assoc c distal tracheoesophageal fistula
Agenesis, or absence, of the esophagus is rare
Lymphocytic esophagitis
Is a pattern of injury, not a dx
- assoc c Crohn dz, GERD, gastroduodenitis, celiac dz, esophageal ca, hiatal hernia, Hashimoto thyroiditis, cirrhosis
- typically have >20 lymphs / hpf, 50-55 lymphs / hpf in papillary areas
Common variable immunodeficiency (CVID)
defective B-cell differentiation cousing hypogammaglobulinemia, sometimes impaired T-cells also
- 2/3 20-yr survival
- pts usually suffer from lots of other immune dz
- can see in intraepithelial lymphs

Esophagitis dissecans superficialis (EDS)
CMV esophagitis

Herpes esophagitis


Candida esophagitis


Esophageal atresia and tracheoesophageal fistula. A) blind upper and lower esophagus c thin cord of CT linking the 2 segments; B) The MC delevopmental abnormality!! has a blind upper segment c fistula bwt lower seg and trachea, C) fistula (wo atresia) bwt patent esophagus and trachea.
Lymphocytic esophagitis

Post-treatment Changes
PDT causes more complications than radiofreq ablation (have more strictures, and can appear similar to GVHD), and more often have "buried" BE, which may be assoc c HG-dysplasia, but usually can be seen endoscopically
Endoscopic Mucosal Resection Specimens
Suck and cut method, that creates an artificial polyp that is then resected
- duplication of muscularis mucosa is a common problem bc some pathologists may interpret it as submucosa, thus leading to dx of submucosal invasion (T1b), when it should really be T1a (restricted to lamina propria); where T1b reqs more aggressive tx
- seen in up to 9/10 specimens
Diathermy from resection causes sample to be convex, and gives the impression that the lateral margins are the deep margins
- should divide mucosa into m1-3, which represents thirds of the mucosal thickness; and if barely penetrates an "m" layer, designates as "sm[x]" where "x" is the invaded layer
Squamous Papilloma
Uncommon, usually incidental, in distal esoph, whites, F>M, assoc irritation, grossly tiny white warty nodule(s)
- may be assoc c dysplasia (not common)
- may be 2/2 reflux or HPV, controversial
- micro: bland polypoid squamous mucosa c fibrovascular core
Giant Fibrovascular Polyp (GFVP)
Rare, b9 pedunculated intraluminal masses from esoph submucosa usually around cervical esoph; can be huge (up to 25 cm) and produce strange sx; imaging key to dx
- usually not bx'd, and bx can obscure dx
- micro: polypoid mass covered in bland squamous epithelium
- may be assoc c atypical lipomatous tumor (MDM2 +)
- tx is surgical
Barrett esophagus (BE)
Complication of chronic GERD
MCC of AC (not SCC); BE is metaplastic columnar epithelium replacing stratified squamous epithelium of distal esophagus
- must be intestinal metaplasia in US (but not in UK or Japan)
- caused by chronic reflux (GERD), but should screen if have multiple risk factors (>50 yo, fat rich caucasian dudes); having Barrett esophagus usually alleviates sx
- on endoscopy see red velvety tongues of mucosa extending from GEJ
- long segment = >3 cm involved; short segment <3 cm (more chance of dysplasia if longer); ultra-short segment = <1 cm
- can cause ulcers, strictures, bleeding; but lesions not always present
- must correlate c endoscopy findings (BE looks like tongues or patches of reddish velvety mucosa); both endoscopic and histologic features required for dx of BE
- inc risk esophageal AC
MC in white males 40-60 yo
Histo changes:
1) Squamous --> columnar metaplasia in distal esophagus above LES
3 types, based on mucin content of columnar-type and goblet cells:
Type 1) Complete metaplasia has absorptive columnar cells and has neutral mucins
- mucosa mimics intestinal epithelium, c brush border, Paneth cells present; usually in gastric cardia c H pylori infx; has no intervening foveolar-type mucin
Type 2) incomplete metaplasia is at least partially secretory and has acidic sialomucins (type II) or sulphomucins (typpe III)
-- incomplete metaplasia may put the pt at more inc risk of dysplasia / carcinoma
2) Goblet cells in esophagus (mucin with slightly bluish tinge) required to say that there's Intestinal metaplasia
3) Dysplasia can be low or high grade, depending on cellular features
- based on 4 main features:
a) surface maturation
- glands normally have larger and more hyperchromatic basal nuclei, whereas the surface nuclei are in a monolayer c polarized basal nuclei
- gastric-type (fundic or cardiac) glands in Barrett's can have larger nuclei, similar size to those at the surface, or surface can have bigger nuclei
b) gland architecture
- relation of the glands and lamina propria and the outline of the glands; crowding of abnormal glands, cribriform glands, custic dilation and necrotic luminal debris are dysplastic features
c) cytologic features
- some degree of nuclear atypia is normal in BE, esp in basal zone and columnar epithelium adjacent to squamous mucosa
- dysplastic cells are usually hyperchromatic
- "normal polarity" is having the long axis of the nucleus perpendicular to the BM; loss of polarity looks more jumbled up
d) inflam and erosions / ulcers
- can make a reparative process look dysplastic
Negative for dysplasia: NC ratio of surface cells is lower than that of deeper glands, has normal architecture c lots of lamina propria bwt glands, nuclear polarity maintained, smooth nuclear membranes
Indefinite for Dysplasia (IND): deep glands show dysplasia but surface is more normal; maybe 2/2 reactive changes; does not have loss of polarity
Low grade dysplasia: has only slight maturation; architecture can be markedly distorted, but should have lamina propria bwt glands; areas c dysplasia and w/o dysplasia should have abrupt transitions; mits can be close to surface; loss of mucin in superficial epithelium common; may look like tubular adenoma from colon
High grade dysplasia: lack of maturation, usually do not have prominent nucleoli, have markedly large hyperchromatic cells, lots of mits, minimal inflam, loss of nuclear polarity
- if high-grade dysplasia is accompanied by an ulcer, must suspect that there is unsampled invasive carcinoma, and request more tissue
- with high-grade dysplasia, also suspect unsampled carcinoma if there is cribriform architecture, dilated tubules c necrotic debris, ulcerations, Pagetoid pattern of spread of dysplastic cells
Dx: Endoscopy shows velvety-red flames of mucosal patches proximal to GE junction
IHC: probably not necessary
- p53 can be (+) in atypia, may use to stratify to high and low risk
- alcian blue (AB) / PAS increases recognition of metaplasia; normally stains gastric foveolar cells, cells in pancreatic acinar metaplasia / heterotopia, esophageal submucosal glands, cells in "multilayered epithelium" (which can be intestinal metaplasia precursor), (decreases chance of misinterpreting cells c cytoplasmic vacuoles as goblet cells)
- (+) superficial and deep CK7 staining c only superficial CK20
-- ( distal gastric metaplasia has patchy superficial and deep CD20 c incomplete intestinal metaplasia and strong superficial and deep CK20 c complete intestinal metaplasia; both have absent or patchy CK7)
- (+) both MUC1 and MUC6 (low sens but high spec)
- (+) staining c AMACR indicative of some degree of dysplasia
Genes: p16 INK4A/CDKN tumor suppressor gene inactivation on chr 9p21; loss of p53 tumor suppressor gene cr p 17p13
- other genetic alterations include MYC gene amplification, microsatellite instability, KRAS mutations, EGFR, CTNNb1, erbB2, MCC and DCC
Tx: PPI's and scope q 2-3 yrs.
- if low grade dysplasia: scope q 6-12 mo.
- if high grade dysplasia: ablation or esophagectomy; in 3 mo
DDx: gastric carditis c intestinal metaplasia
Variant Patterns of Dysplasia
Reparative lesions have more prominent nucleoli and less hyperchromasia than high-grade dysplasia
Basal crypt dysplasia (BCD) shows surface maturation with architectural / cytologic dysplasia w/o inflam in the crypts
- architecturally has crypt budding / branching +/- crowding c glandular irregularities
- cytologically, BCD has inc N/C, pleomorphism, hyperchromatic, mucin depletion, lots o mits
- may have inc risk HG-dysplasia or AC, but not entirely certain
- should tx as LG-dysplasia
Small cell pattern has lots of tiny glands that have bizarre nuclear features at high mag
Hypermucinous change can be assoc c carcinoma, and should thus be dx'd as either LG-dysplasia or IND
Pts taking colchicine can have ringed mits or HG-dysplasia
Esophageal Cancer Overview
Pts get dysphagia, which leads to weight loss
- SCC is MCC worldwide, AC in the USA and western nations
Leiomyoma MCC benign cancer, granular cell carcinoma 2nd MCC
- may also get
Rsk factors: ABCDEF **** Alcohol / Achalasia, Barrett's esophagus, Cigarettes, Diverticuli, Esophageal web, Familial ****
Intramucosal Adenocarcinoma
Defined as invasion through BM into lamina propria or muscularis mucosa, but not farther
- can be difficult to distinguish from high-grade dysplasia
- characteristically has back-to-back glands, prominent nucleoli, syncytial growth pattern, effacement of lamina propria, single cells in lamina propria (invasion into lamina propria in the colon is equivalent to high-grade dysplasia, but not here in the esophagus)
- desmoplasia usually not very prominent
- must tell clinician if there is lymphovascular invasion bc will change tx, pt may have positive LNs
Tx: similar to high-grade dysplasia, tx is endoscopic
Adenocarcinoma
MCC esophageal cancer in USA (or equal to SCC [???])
- usually occurs in distal 1/3 of esophagus, pts > 60 yo
- grossly is a firm whitish lesion at distal 1/3 of esophagus
Risk factors: obesity, reflux -> Barrett's, cigarettes, white people
- up to 3/5 pts c HG-dysplasia develop AC in 5 yrs (women are slightly less likely)
- wine drinking may be protective, also diets rich in fruits and veggies
- some serotypes of H pylori assoc c dec risk of AC bc cause gastric atrophy and dec gastric acid secretion and dec reflux
Genes: p53 gene mutations sequence, p16, cyclin E, RB, cyclin D1 /E, HER2
- early ib us TP53 and CDKN2A (aka p16/INK4alpha) mutations
- later get amplication of EGFR, ERBB2, MET, cyclin D1 and cyclinE
Micro: best predictors of findings AC in a resection specimen from biopsy are ulceration, syncytial glands with cribriform lumens, and intraluminal necrotic debris; intraepithelial neuts in areas of dysplasia and extension of neoplastic glands to b9 squamous epithelium are also highly predictive
- look like AC in other organs, having either glandular structures or mucin production
- can be classified as papillary, tubular, signet ring and can have endocrine cells, Paneth cells or predominance of mucin (not important to classify, has no real value)
- identifying an adjacent HG-dysplasia or in-situ lesion assures that lesion is primary from esophagus and not metastatic (ie from lung)
- resection is usually done after chemo and radiotx
- adenosquamous CA is rare in esophagus
- adenoid cystic CA is very rare, but may be found in middle 1/3
IHC: (+) CK7/19, PAS, AMACR, mucicarmine
- negative CK20
- stains not usually necessary
Tx: surgery and chemo
- tell clinician if it is signet ring, bc pt will get esophagogastrectomy
Px: depends on LN involvement (if it has spread, <25% 5-yr survival; 4/5 5-yr survival if has not spread)
- px is worse if assoc c Barrett esophagus
- usually at advanced stage at time of dx, after tumor has spread to lymphatic vessels, and the 5-yr survival usually <25%; if caught early and limited to mucosa or submucosa, 5-year-survival ~80%
Squamous Cell Carcinoma
MCC esophageal cancer worldwide; usually in older black males, incidence is decreasing (vs AC which is increasing)
- found in upper 2/3, usually mid esophagus
- 60% have regional LN mets at time of dx, which correlates to depth of invasion
- seen in adults >45 yo, 4M:1F
Risk factors: smoking, EtOH, nitrosamines, very-hot liquid consumption (anything that causes chronic irritation), prior radiation therapy, achalasia, esophageal diverticula, nonepidermolytic palmoplantar keratoderma, low socioeconomic status, Plummer-Vinson syndrome, HPV (?), M>F
- Barrett esophagus (BE) is not a risk factor for SCC (but is for AC)
Micro: similar to elsewhere, usually well-diff and keratinized
- can be spindle celled (more difficult to dx) or basaloid
- finding dysplastic squamous epithelium close to lesion helpful
IHC: (+) p64, CK5/6
- neg S100
Genetics: loss of p16, p53, Rb, E-cadherin and NOTCH1 tumor suppressors; SOX2 amplification, polymorphisms in ALDH gene for aldehyde dehydrogenase seen in Asians (also causes Asian glow from acetaldehyde accumulation following EtOH ingestion)
Tx: Rads and chemo, someitmes resection (usually palliative)
Px: Very poor; <20% 5-yr survival
- 5-yr survival ~75% in pts c superficial esophageal SCC
Neuroendocrine Tumors
Classified as NE tumors grade 1 and 2 (carcinoid, atypical carcinoid) and NE carcinoma (large and small cell types)
- very rare in esophagus
Well-diff NE tumors (carcinoids) usually polypoid in esophagus and seen in lamina propria; c uniform bland tumor cells in insular pattern and solid-cribriform growth; can be assoc c heterotopic oxyntic mucosa; (+) keratin, SYN, CHR
- graded by # mits: G1 = <2 mits / 10 hpf or <2% Ki67
-- G2 = 2-20 mits / 10 hpf or up to 20% Ki67
NE carcinoma (Grade 3) high grade and divided into small and large cell types; both are aggressive, usually in men
- can have AC or SCC differentiation
- >20 mits / 10 hpf or >20% Ki67
Granular Cell Tumor (GCT)
Benign (may met if high mit activity); rare, derivative of Schwann cells or neuroectoderm MC in tongue / skin, also esophagus sometimes
- grossly firm, whitish lesions
Micro: sheets / nests of pink cells c small nuclei and lots of red cytoplasm, similar to other sites
- may mimic SCC if lots of pseudoepitheliomatous hyperplasia of squamous epithelium
DDx: rhabdomyoma, melanoma
IHC: (+) S100, PAS-diastase resistant, CD68, calretinin, inhibin, myelin basic protein
- neg muscle and myeloma markers
Rhabomyoma
Usually in the heart where assoc c TS, can be extracardiac, which are broken down into Adult (AR), Fetal (FR, classic or intermediate types), or Genital Rhabdomyomas
- MC type seen in esophagus is AR, where is a slow growing submucosal mass
- usually encapsulated, tan-brown, rubbery, no necrosis
Micro: lobular c close-packed polygonal cells c lots of red granular cytoplasm (2/2 intracellular myofibril packing) c peripheral nuclei
- can have glycogen or lipid cytoplasmic vacuoles
- may have intranuclear inclusions as well
IHC: (+) Desmin, MSA, myoglobin, CD56, fetal myosin
- neg CK, EMA, GFAP, CD68, LCA, variable S100
Leiomyoma
B9, MC spindly tumor of esophagus, usually younger pts, M>F
(+) SMA, and desmin, negative CD117 and CD34
- rarely can find leiomyosarcoma
Esophageal GIST
very rare, older men, lower 1/3, morphologically similar to GISTs,
(+) CD117 and CD34
Melanoma
Rare to find primary melanoma of esophagus, M>F, most are pigmented, usually bulky polypoid masses
(+) S100, MART, HMB45, MelanA, CD117 (in 2/5)
- poor px
Nerve Sheath Tumors
very rare in esophagus, overlapping features c stomach and colon
(+) S100
- neg melanoma markers
Squamous papilloma

Barrett esophagus. A) Normal GEJ, B) Barrett esophagus. Note the small islands of residual pale squamous mucosa within the Barett mucosa. C) Histologic appearance of the GEJ in Barrett esophagus. Note the transition bwt esophageal squamous mucosa (left) and Barrett metaplasia c abundant metaplastic goblet cells (right)

B) Incomplete IM or specialised columnar epithelium is differentiated from the complete IM subtype by the presence of goblet cells intermixed with mucin-secreting columnar-appearing non-goblet cells staining red and blue by the alcian blue (pH 2.5)-periodic acid Schiff stain (B).
A) Complete intestinal metaplasia (IM) goblet cells stained red or blue by alcian blue (pH 2.5)-periodic acid Schiff (PAS) stain and by presence of absorptive non-goblet cells.


Dysplasia in Barrett esophagus. A) Abrupt transition from Barrett metaplasia to low-grade dysplasia (arrow). B) Architectural irregularities, including gland-within-gland, or cribriform profiles in high-grade dysplasia

Intramucosal adenocarcinoma in Barrett esophagus

Adenocarcinoma usually occurs distally and, as in this case, often involves the gastric cardia

Esophageal AC organized in back-to-back glands

Squamous cell carcinoma is mC iin the mid-esophagus, where it commonly causes strictures

SCC composed of nests of malignant cells that partially recapitulate the organization of squamous epithelium

Granular Cell Tumor

References
1. Histology from https://www.proteinatlas.org/learn/dictionary/normal
2. Stancu M. Pill Esophagitis. http://www.universitypathologists.com/education/case-of-the-month/june-2010
3.
